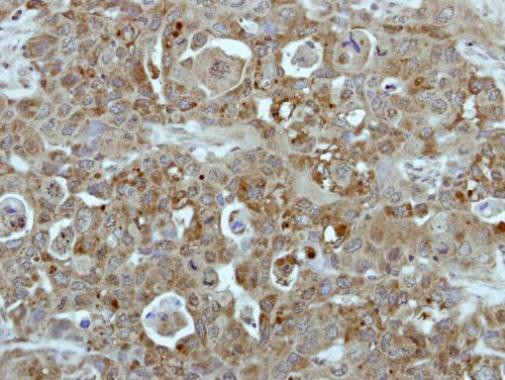
BCR Antibody in Immunohistochemistry (Paraffin) (IHC (P))

Search
Invitrogen
BCR Polyclonal Antibody
{{$productOrderCtrl.translations['antibody.pdp.commerceCard.promotion.promotions']}}
{{$productOrderCtrl.translations['antibody.pdp.commerceCard.promotion.viewpromo']}}
{{$productOrderCtrl.translations['antibody.pdp.commerceCard.promotion.promocode']}}: {{promo.promoCode}} {{promo.promoTitle}} {{promo.promoDescription}}. {{$productOrderCtrl.translations['antibody.pdp.commerceCard.promotion.learnmore']}}


Please note: We are reviewing Western blot images included in the antibody testing data in our catalog, including those provided by third parties. Unless expressly labeled or annotated as “raw-unedited”, Western blot images included in the antibody testing data in our catalog may have been edited, optimized or otherwise adjusted for presentation.
产品信息
PA5-29334
种属反应
宿主/亚型
分类
类型
抗原
偶联物
形式
浓度
规格
纯化类型
保存液
内含物
保存条件
运输条件
RRID
产品详细信息
Recommended positive controls: Molt-4.
Predicted reactivity: Mouse (96%).
Store product as a concentrated solution. Centrifuge briefly prior to opening the vial.
靶标信息
A reciprocal translocation between chromosomes 22 and 9 produces the Philadelphia chromosome, which is often found in patients with chronic myelogenous leukemia. The chromosome 22 breakpoint for this translocation is located within the BCR gene. The translocation produces a fusion protein which is encoded by sequence from both BCR and ABL, the gene at the chromosome 9 breakpoint. Although the BCR-ABL fusion protein has been extensively studied, the function of the normal BCR gene product is not clear. The protein has serine/threonine kinase activity and is a GTPase-activating protein for p21rac. Two transcript variants encoding different isoforms have been found for this gene.
⚠WARNING: This product can expose you to chemicals including mercury, which is known to the State of California to cause birth defects or other reproductive harm. For more information go to www.P65Warnings.ca.gov.
仅用于科研。不用于诊断过程。未经明确授权不得转售。
篇参考文献 (0)
生物信息学
蛋白别名: ABL; BCR protein; bcr/abl; Breakpoint cluster region protein; c-ABL; c-abl oncogene 1; EC 2.7.11.1; JTK7; p150; Renal carcinoma antigen NY-REN-26; RP11-83J21.1; v-abl
基因别名: BCR; BCR1; D22S11
Entrez Gene ID: (Human) 613